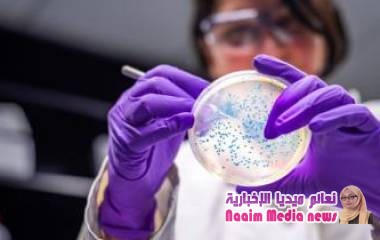
بكتيريا مقاومة للعقاقير تنتشر في مستشفيات أوروبا وإسرائيل

مشاركات وتطبيقات متعلقة بالوسم وفاة - الصفحة 25
مشاركات وتطبيقات متعلقة بالوسم وفاة - الصفحة 25 الصفحة 25 استعرض كافة المشاركات والتطبيقات المتعلقة بالوسم وفاة
شيعت إحدى قرى مدينة المحلة، بمحافظة الغربية وسط دلتا...
أعلنت المنظمة الدولية للهجرة التابعة للأمم المتحدة،...
متحدث فريق تقييم الحوادث في اليمن يستعرض نتائج تقييم...
خلصت دراسة أوروبية موسعة إلى أن البكتيريا المقاومة...
في الذكرى العشرين لتولي الملك محمد السادس حكم المغرب،...
كم تساوي أو بالأحرى، هل تمثل إجابة هذا السؤال المبلغ...
تشهد محافظة شبوة على وجه العموم أمطار غزيرة خلفت سيول...
مكتب حقوق الأنسان بأمانة العاصمة يكشف عن أكثر من ثلاثة...
ألقي القبض على مهرب مخدرات مشتبه به صدم بشاحنة محملة...
دشن البرنامج الوطني لمكافحة الملاريا وحمى الضنك في...
قتل 26 شخصا على الأقل، وأصيب عشرات بجروح فيما يشتبه...
توفي صاحب سلسلة المطاعم الهندية العالمية سارافانا...